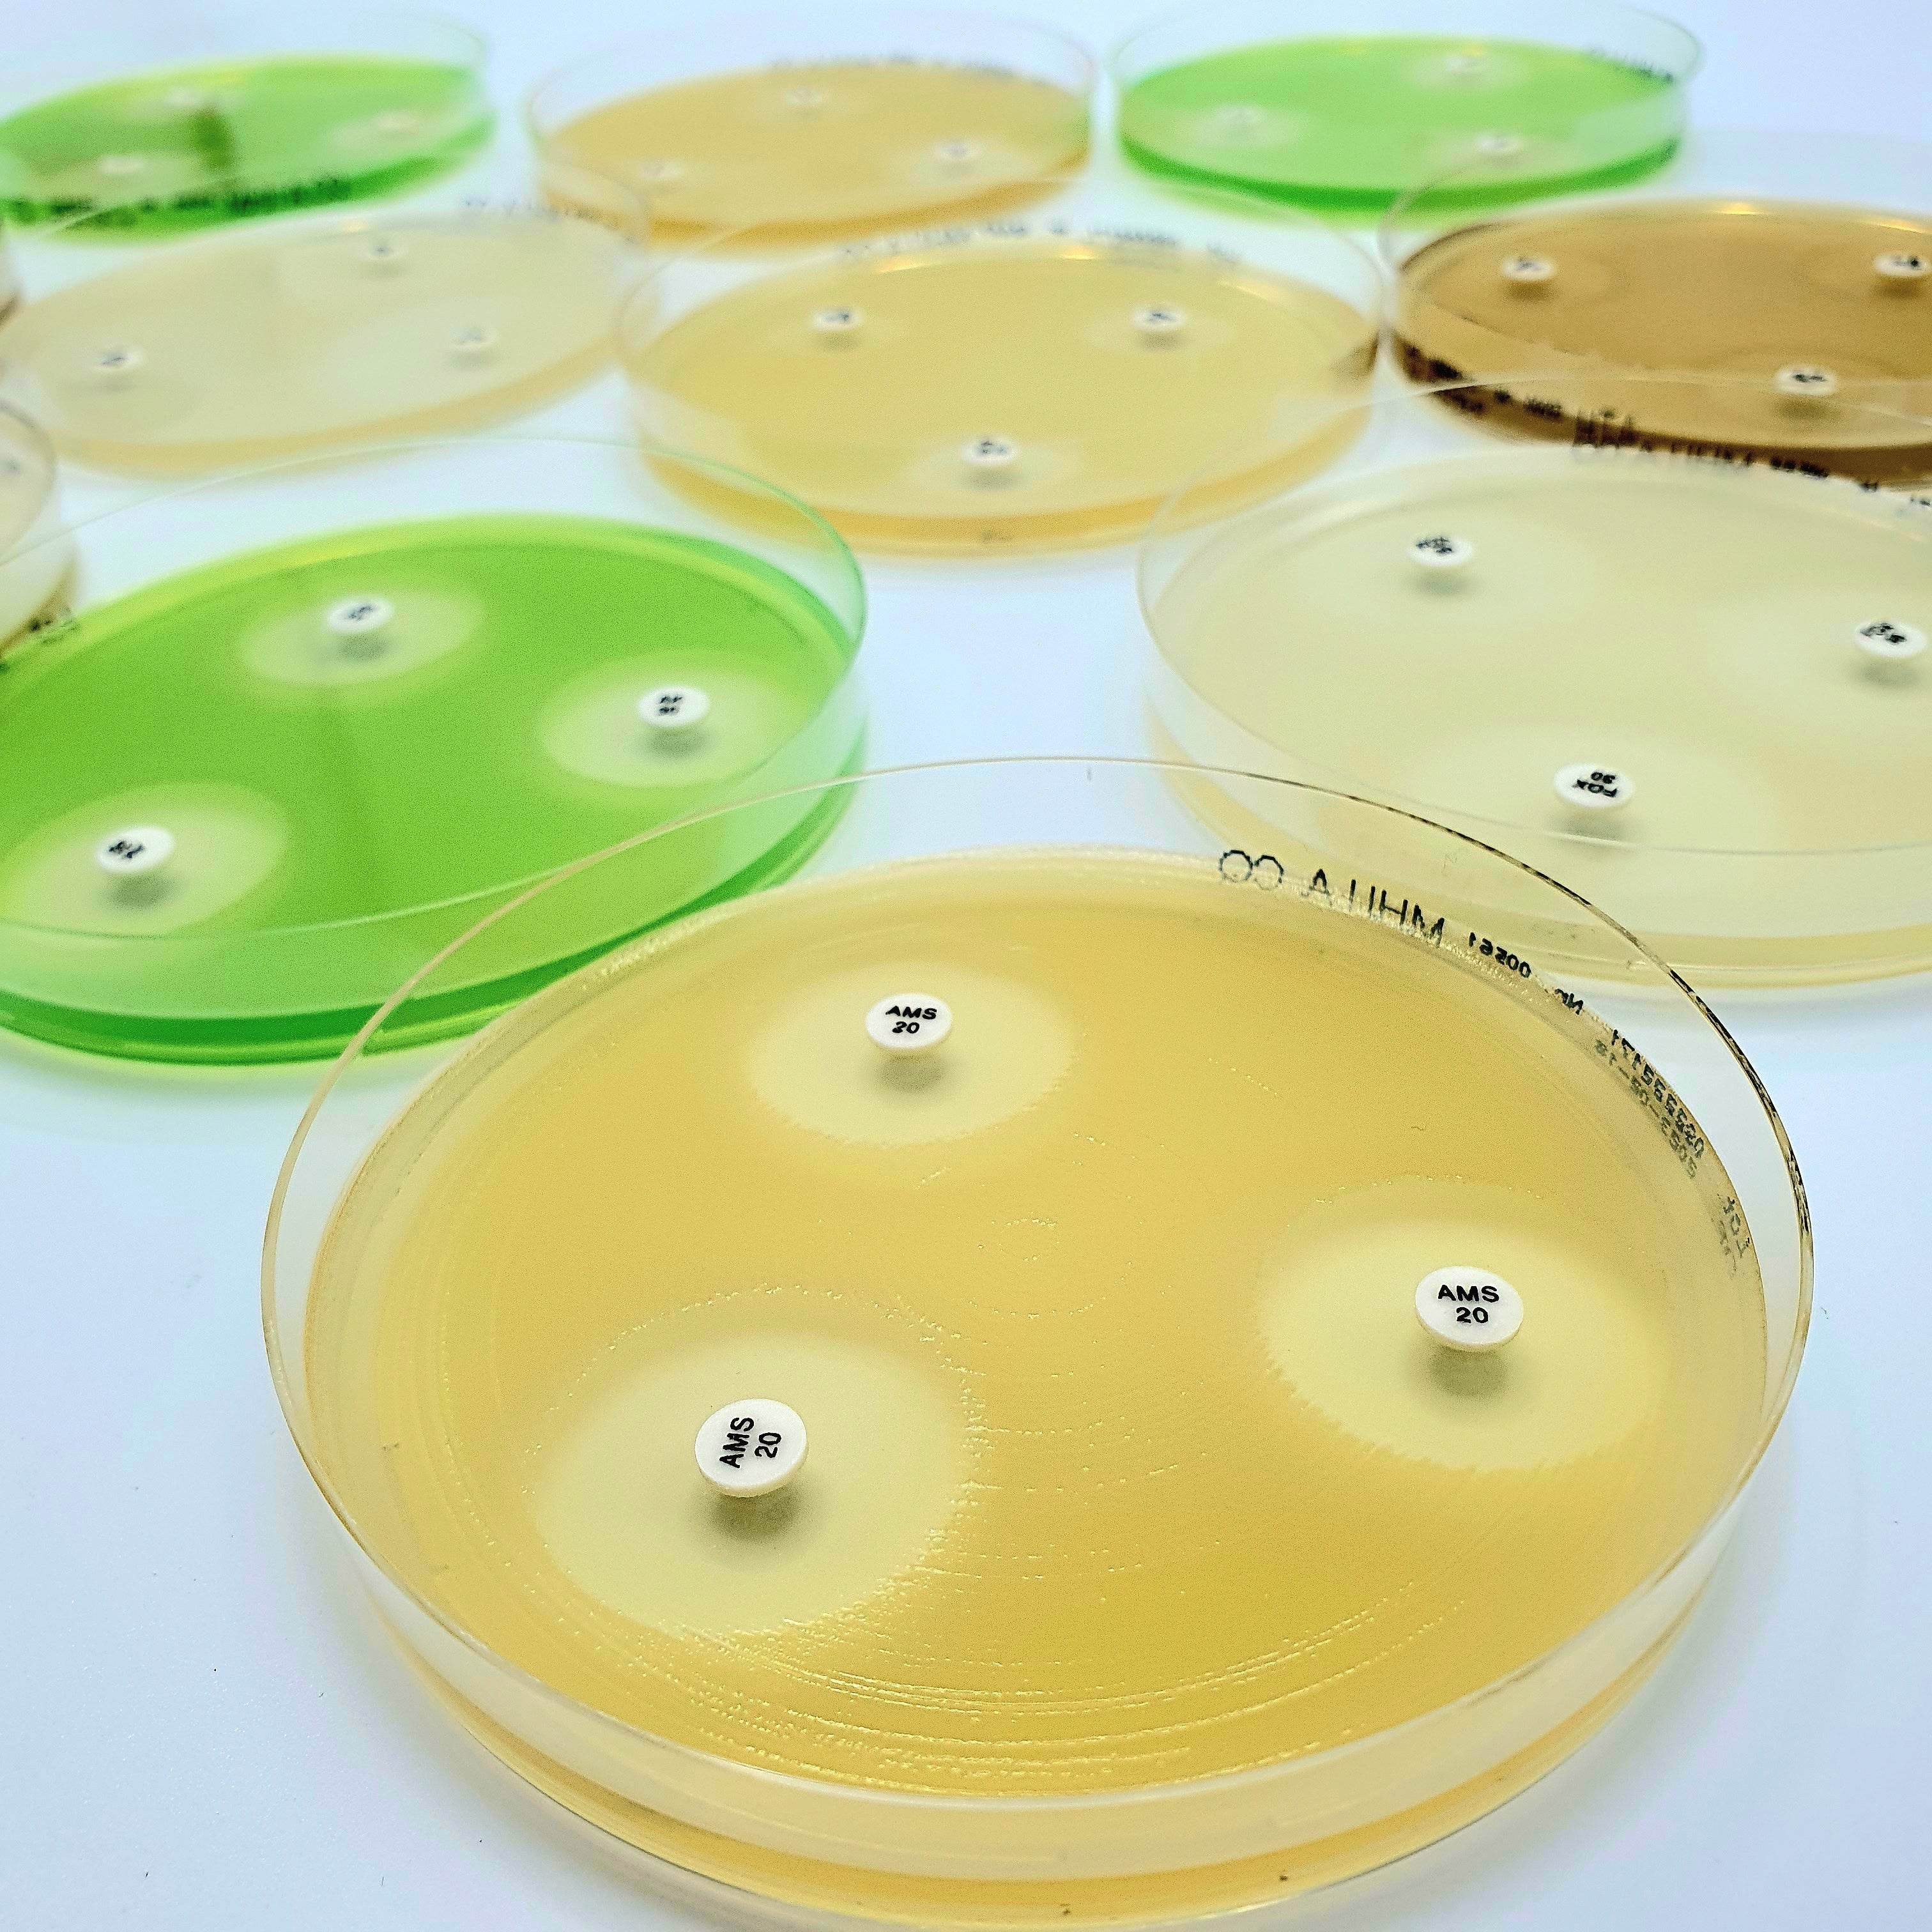

Description
Cefazolin KZ 30 µg Antibiotic Disc are paper discs with special features, that are impregnated with Cefazolin KZ 30 µg antibiotic and used for the susceptibility test according to the Kirby-Bauer antibiotic testing (KB testing or disk diffusion antibiotic sensitivity testing). Antibiotic Disc are available in a large variety of configurations. Each configuration is available in packages of 50 and 250 tests.
Disclaimer: This product is for microbiology testing and laboratory use only. Not intended for human or veterinary treatment.Payment & Security
Your payment information is processed securely. We do not store credit card details nor have access to your credit card information.